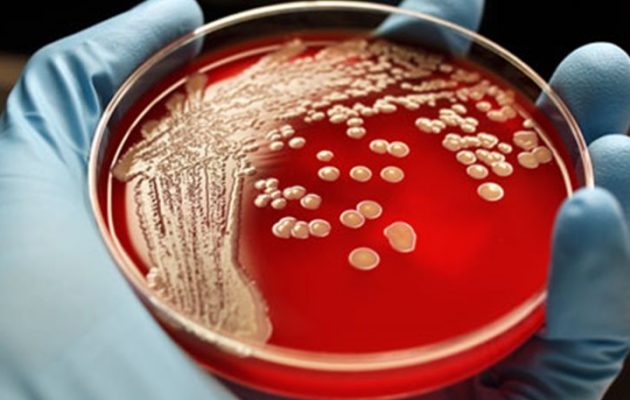

ΔΕΙΤΕ ΠΡΩΤΟΙ ΟΛΑ ΤΑ ΝΕΑ ΤΟΥ TRIBUNE ΣΤΟ GOOGLE NEWS
ΔΕΙΤΕ ΠΡΩΤΟΙ ΟΛΑ ΤΑ ΝΕΑ ΤΟΥ TRIBUNE ΣΤΟ GOOGLE NEWS

ΔΕΙΤΕ ΠΡΩΤΟΙ ΟΛΑ ΤΑ ΝΕΑ ΤΟΥ TRIBUNE ΣΤΟ GOOGLE NEWS
ΔΕΙΤΕ ΠΡΩΤΟΙ ΟΛΑ ΤΑ ΝΕΑ ΤΟΥ TRIBUNE ΣΤΟ GOOGLE NEWS 
Εάν δεν αλλάξει κάτι μέχρι το 2050, ένας άνθρωπος θα πεθαίνει από τα μικρόβια κάθε τρία δευτερόλεπτα, σύμφωνα με επίσημη έκθεση διεθνούς επιρροής.
Η διεθνής έκθεση επισημαίνει ότι χρειάζεται ένα πλάνο επένδυσης πολλών δισεκατομμυρίων δολαρίων προκειμένου να αποφευχθεί η επιστροφή στην «σκοτεινή εποχή».
Η έκθεση καλεί επίσης σε μία «επανάσταση» σε σχέση με τον τρόπο που χρησιμοποιούνται τα αντιβιοτικά, να αλλάξει δηλαδή ο τρόπος χρήσης τους και μια μεγάλης έκτασης καμπάνια ώστε να εκπαιδευτεί εκ νέου ο κόσμος.
Μέχρι τώρα, η επίσημη αυτή έκθεση έχει δεχθεί πολλές επικρίσεις, με το επίκεντρο της κριτικής να εστιάζει στο ότι η έρευνα δεν έχει κάποια σοβαρή πρόταση.
Το ζήτημα της ανθεκτικότητας των λοιμώξεων στα αντιβιοτικά είναι τεράστιο, με την ανθρωπότητα να μην μπορεί να αντεπεξέλθει. Αποτελεί ζήτημα εξίσου σημαντικό με την τρομοκρατία λένε κάποιοι.
Το βασικό πρόβλημα βέβαια είναι ότι απλά δεν αναπτύσσονται καινούρια αντιβιοτικά και χαραμίζουμε αυτά που ήδη έχουμε.
Από τη στιγμή που ξεκίνησε η κριτική για τη μικροβιακή αντοχή στα μέσα του 2014, πάνω από ένα εκατομμύριο άνθρωποι πέθαναν από τέτοιου είδους λοιμώξεις.
Η αναθεώρηση αναφέρει ότι η κατάσταση θα επιδεινωθεί και από το 2050 αναμένεται να πεθαίνουν κάθε χρόνο 10 εκατομμύρια άνθρωποι από ανθεκτικές μικροβιακές λοιμώξεις.





























































